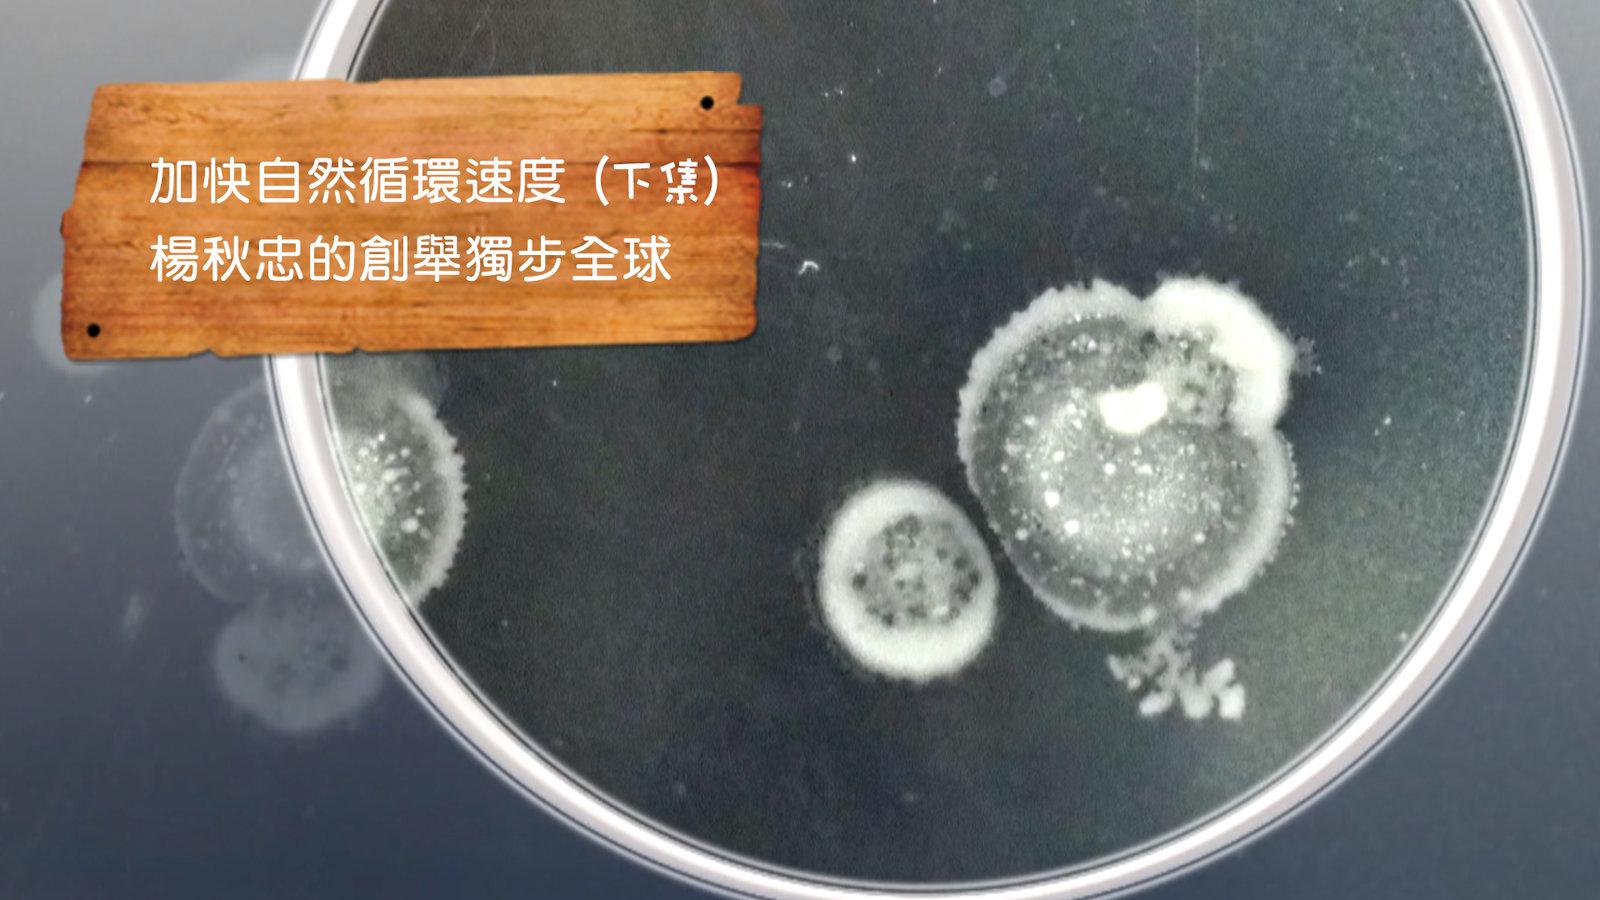

孫大明走遍世界觀察世界各地,不管是政府或是民間力量,對於保育稀有動物或是鳥類的重視程度,有些已經超越經濟利益的考量,但卻帶來另一項不可思議的觀光經濟。
---------------------
展現台灣各行各業用心的經營者,努力創造台灣新契機,新世界心台灣,展現島民的勤奮與生命力,創造不同的新視野,讓 世界看見台灣。
美麗心台灣FB粉絲團
看下一集

【高雄茄萣區】拍鳥愛鳥生態保育者 實際救援行動 |環境保護 |美麗心台灣(210)中

【台南中西區】瞬間永恆的鳥類生態攝影展 |環境保護|美麗心台灣(210)下

【台南關廟】退休副廠長 研發新品種紅玉筍(上集)|有機無毒 |美麗心台灣(211)上

【台南關廟】退休副廠長 研發新品種紅玉筍(下集)|有機無毒 |美麗心台灣(211)中

【屏東竹田】黃穎推展金銀花 轉移社區老人的生活重心| 有機無毒 |美麗心台灣(211)下

【台中市西區】追尋身土不二法則,探究食物源頭|環境保護 |美麗心台灣(212)上

【台中市西區】追尋身土不二法則,探究食物源頭|環境保護 |美麗心台灣(212)中

【台中市西區】追尋身土不二法則,探究食物源頭|環境保護|美麗心台灣(212)下

【台中市】加快自然循環速度 楊秋忠的創舉獨步全球(上集) | 環境保護 | 美麗心台灣(213)上
【台中市】加快自然循環速度 楊秋忠的創舉獨步全球(下集)| 環境保護 | 美麗心台灣(213)中

【新竹竹北】下腳料處理高效率 肉品市場環境改觀 |環境保護 | 美麗心台灣(213)下

【台南中西區】黑琵先生王徵吉 用生命做保育紀錄 | 環境保護 |美麗心台灣(214)上

【台南中西區】黑琵先生王徵吉 用生命做保育紀錄 | 環境保護 |美麗心台灣(214)中

【台南中西區】黑琵先生王徵吉 用生命做保育紀錄 | 環境保護 |美麗心台灣(214)下

【台南中西區】用生命保育黑琵計畫的最後一哩路 | 環境保護 |美麗心台灣(215)上

【台南中西區】用生命保育黑琵計畫的最後一哩路 | 環境保護 |美麗心台灣(215)中








